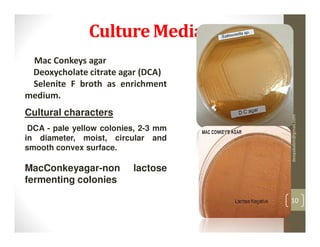
Culture Medias
 Mac Conkeys agar
 Deoxycholate citrate agar (DCA)
 Selenite F broth as enrichment
medium.
Cultural characters




                                      deepababin@gmail.com
 DCA - pale yellow colonies, 2-3 mm
in diameter, moist, circular and
smooth convex surface.

MacConkeyagar-non         lactose
fermenting colonies

                                      10
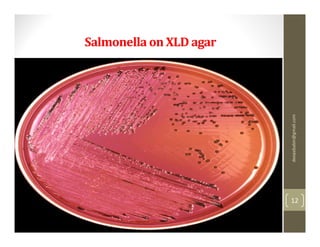
Salmonella on XLD agar




                         deepababin@gmail.com
                         12
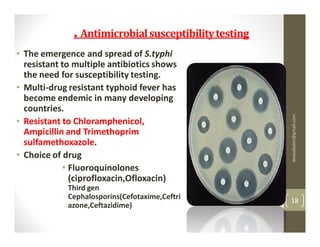
. Antimicrobial susceptibility testing
• The emergence and spread of S.typhi
  resistant to multiple antibiotics shows
  the need for susceptibility testing.
• Multi-drug resistant typhoid fever has
  become endemic in many developing
  countries.




                                                       deepababin@gmail.com
• Resistant to Chloramphenicol,
  Ampicillin and Trimethoprim
  sulfamethoxazole.
• Choice of drug
            • Fluoroquinolones
              (ciprofloxacin,Ofloxacin)
             Third gen
             Cephalosporins(Cefotaxime,Ceftri          18
             azone,Ceftazidime)

The 20-year-old male student presented with a week of fever showing a step-ladder pattern, along with mild hepatomegaly. This suggests a provisional diagnosis of enteric fever. Diagnosis can be confirmed through microbiological investigation of blood, bone marrow, blood clots, stool, or urine cultures, which ideally should be done in the first week of illness. Antibiotic susceptibility testing is important as multidrug-resistant strains of Salmonella Typhi have emerged. Prevention emphasizes good sanitation and vaccination.